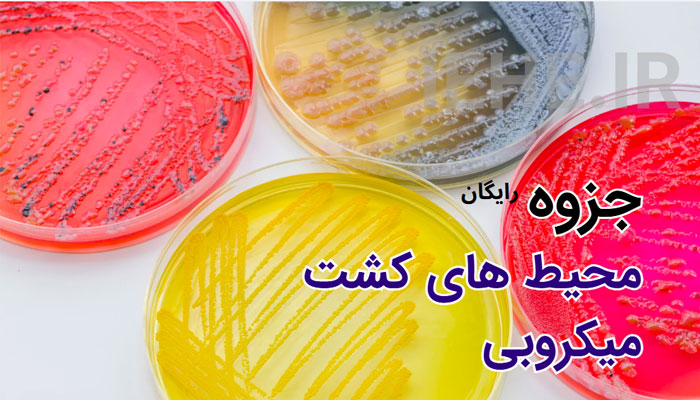

جزوه محیط های کشت باکتری PDF
- مناسب برای : افزایش اطلاعات عمومی در مورد محیط های کشت | ارائه و پرزنت | دانشجویان بهداشت محیط و میکروبیولوژی و آزمایشگاه
- تعداد صفحات : ۵۵ اسلاید
- زبان : فارسی
تعریف محیط کشت
از آنجا که میکروب یک موجود تک سلولی بوده و قادر است کلیه اعمال حیاتی خود را مستقلا انجام دهد بدون آنکه نیاز به سلول دیگری داشته باشد .این اصل بیانگر آن است که میکروب ها هم احتیاج به غذا و آب و مواد آلی و معدنی دارند. محیطی مغذی که حاوی کلیه احتیاجات یک میکروب اعم از مواد غذایی و عناصر و غیره باشد که موجب رشد آن میکروب شود را اصطلاحا محیط کشت می گویند. این محیط کشت می تواند بصورت دست ساز بوده یا یطور طبیعی یعنی داخل سلولهای بدن یک جانور باشد.
هدف از کشت باکتری ها
- شناسایی باکتری ها
- تهیه تعداد فراونی از کلونی های یکسان
- جدا کردن باکتری های مخلوط (MIX )
- شمارش باکتری ها
- بررسی های آنتی ژن های باکتریایی و تهیه واکسن
ترکیبات محیط های کشت و شرایط
- احتیاجات غذایی: منابعی چون کربن، نیتروژن، فسفر، گوگرد، املاح معدنی و فاکتورهای رشد
- شرایط فیزیکی : دما، PH، شرایط اتمسفریک (اکسیژن، دی اکسید کربن)
تاریخچه
- لویی پاستور: استفاده از محیط های مایع ساخته شده از عصاره گوشت
- روبرت کخ: استفاده از تکه های سیب زمینی
- والتر هس: استفاده از آگار برای جامد کردن محیط کشت
برای مشاهده جزوه کامل محیط های کشت باکتری جزوه رایگان را می توانید از باکس دانلود زیر دریافت کنید. در صورت داشتن هرگونه مشکل در دریافت این فایل می توانید در کامنت ها (دیدگاه ها) این مطلب با ما در میان بگذارید.ضمنا اگر این اشتراک برای شما سودمند بود حتما دیدگاه خود را بیان نمایید.















بدون دیدگاه
دیدگاه خود را بنویسید